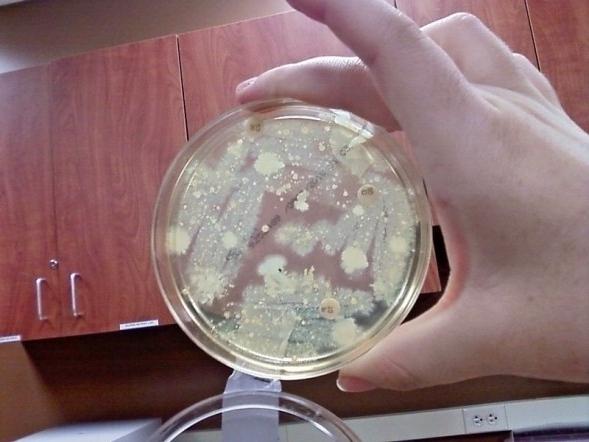

Кокковая флора – это патогенные бактерии
Внутри нашего организма живет множество микроорганизмов. Находятся они в наших органах, на слизистых, коже. Бактерии, живущие с нами на протяжении всей нашей жизни, могут быть хорошими и плохими. Полезные находятся в кишечнике, помогают переваривать пищу, контролировать количество токсичных веществ в организме. Но есть вредные, к таким относится коковая флора. Она живет во влагалище женского организма и влияет на уровень кислотно-щелочного баланса.

Кокки представляют собой бактерии шаровидной формы. Это довольно обширное семейство. К его представителям можно отнести стрептококки, стафилококки и гонококки. Стрептококки — это шаровидные бактерии. Селятся они в основном на слизистой верхних дыхательных путей и вызывают ангину, скарлатину. Стафилококки — самые опасные из всех. Они становятся причиной очень серьезных заболеваний, поражают нервную систему, кожные покровы, могут селиться и на внутренних органах. Гонококки — это возбудители гонореи, дающей осложнения на суставы и сердце. При несоблюдении мер предосторожности можно "приобрести" такую болезнь, как гонококковая ангина.
Кокки устойчивы к внешней среде
Все бактерии этого семейства очень устойчивы. Чтобы их уничтожить, нужно хорошенько постараться. Кокки прекрасно переносят
Признаки увеличения кокковой флоры
Кокковая флора — это медицинский термин, обозначающий увеличение количества кокков на слизистой влагалища. Когда бактерии начинают быстро размножаться, то страдает благоприятная флора. Кокковая среда повышает кислотность. Это приводит к поражению внутренних органов. Признаками того, что кокковая флора разрастается, может служить зуд во влагалище, обильные выделения, жжение. Все это признаки кольпита — воспаления слизистой влагалища. Но если вы обнаружили у себя эти симптомы, необходимо идти к врачу. Но чаще всего кокки себя ничем не проявляют. Раздражая слизистую, они являются причиной эрозии шейки матки, возникновения цистита, создают благоприятные условия для возникновения кандидоза.
Причины увеличения кокковой флоры
Если обнаружилась кокковая флора в мазке, в панику сразу впадать не стоит. Но не стоит и недооценивать серьезность положения. К увеличению кокков ведет лечение антибиотиками и снижение сопротивляемости организма, ношение тесного нижнего белья. В равной степени к разрастанию патогенной флоры приводит как чрезмерное увлечение гигиеной половых органов, так и недостаточность ее. В первом случае ослабляются защитные лактобактерии, во втором создаются благоприятные условия для развития вредной флоры.

Лечиться должны оба партнера
Кокковая флора передается и половым путем. Лечение этого неприятного недуга - дело не только женщины, но и ее партнера. Если будет лечиться лишь женщина, она тут же будет заражать своего мужчину.
Похожие статьи
- Лептотрикс в мазке: что это такое, причины, симптомы и лечение
- Коккобациллярная флора: причины появления, расшифровка анализа и лечение
- Мазок на степень чистоты: норма, расшифровка
- Лейкоциты в мазке: норма и отклонение. Мазок на флору
- E. coli – что это такое? Виды, симптомы и лечение
- Копрограмма: расшифровка лабораторного исследования
- Колиформные бактерии - это что такое?